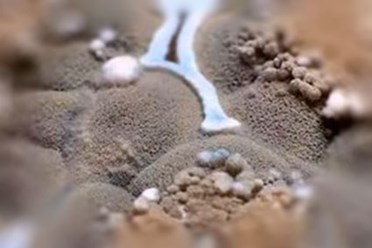
Бороться с плесенью. Безопасно, Гарантия до 3 лет. Профессионалы.

Эко СлужбаNW ООО

- +7 (499) 350-00-98 — многоканальный
Сайт: eko-sluzhbanw.ru
Электронная почта: ecosluzhbanw@mail.ru
Часы работы
Понедельник-воскресенье – круглосуточно
Фотогалерея
Отзывы о Эко СлужбаNW, ООО
К сожалению, нашими пользователями пока еще не было оставлено ни одного отзыва о компании Эко СлужбаNW, ООО. Вы можете быть первым и оставить свой отзыв:
Новости компании
Резиновые уточки – рассадник плесени. Купание со смертельной угрозой. Опаснейшее заражение через органы пищеварения. Иммунитет детей не справляется с плесенью.

Плесень «разгулялась» в новой квартире. Утепление швов застройщиком не дали результата. Обработка Белизной и Доместосом не спасла дорогостоящий ремонт.

Молодая семья сразу после свадьбы переехала в отдельную городскую квартиру. Вскоре на свет появился первенец. Здоровьем малыш не отличался. Простуда преследовала постоянно.
О компании
Удаление плесени.
Гарантированное уничтожение тараканов, клопов, блох, насекомых, грызунов.
Дезинсекция, Дезинфекция, Дератизация ваших квартир.
Сертифицированные препараты европейских и российских производителей, используемые препараты для борьбы с вредителями безопасны для вас, ваших детей и животных. 4 класс безопасности.
Быстро, Надежно и Эффективно.
100% Гарантия на свои работы. Конфиденциальность.
Дипломированные специалисты.
Работаем круглосуточно
Фото
Товары и услуги
Гарантированное уничтожение тараканов в квартирах, домах, гостиницах, хостелах, бытовых и производственных помещениях. Дипломированные специалисты. Консультация бесплатно.
Услуги по дезинсекции, дезинфекции, дератизации квартир, частных домов, предприятий.
Используемые препараты безопасны для ваших детей и животных.
Работаем круглосуточно.
Лояльные цены.
Быстро, надежно, эффективно. Выезд в день звонка.
100% Гарантия до 3 лет. Конфиденциальность.
http://eko-sluzhbanw.ru/nashi-tseny/dezinsektsiya-tsena
Сферы деятельности
Новости
85-
7 ИЮНРезиновые уточки – рассадник плесени. Купание со смертельной угрозой. Опаснейшее заражение через органы пищеварения. Иммунитет детей не справляется с плесенью.
-
15 МАЯПлесень «разгулялась» в новой квартире. Утепление швов застройщиком не дали результата. Обработка Белизной и Доместосом не спасла дорогостоящий ремонт.
Кратко об организации
Организация ООО Эко СлужбаNW из Москвы может предложить покупателям товары и услуги в рубрике Дезинфекция, дератизация и дезинсекция. Расположена по адресу Строительный проезд, стр. 3 в районе Южное Тушино, ближайшая станция метро - Сходненская (1.6 км). Связаться с представителем фирмы Эко СлужбаNW, чтобы получить ответ на Ваш вопрос, вы можете по телефону +7 (499) 3500098, по e-mail ecosluzhbanw@mail.ru, на сайте eko-sluzhbanw.ru, в социальных сетях , , , , .